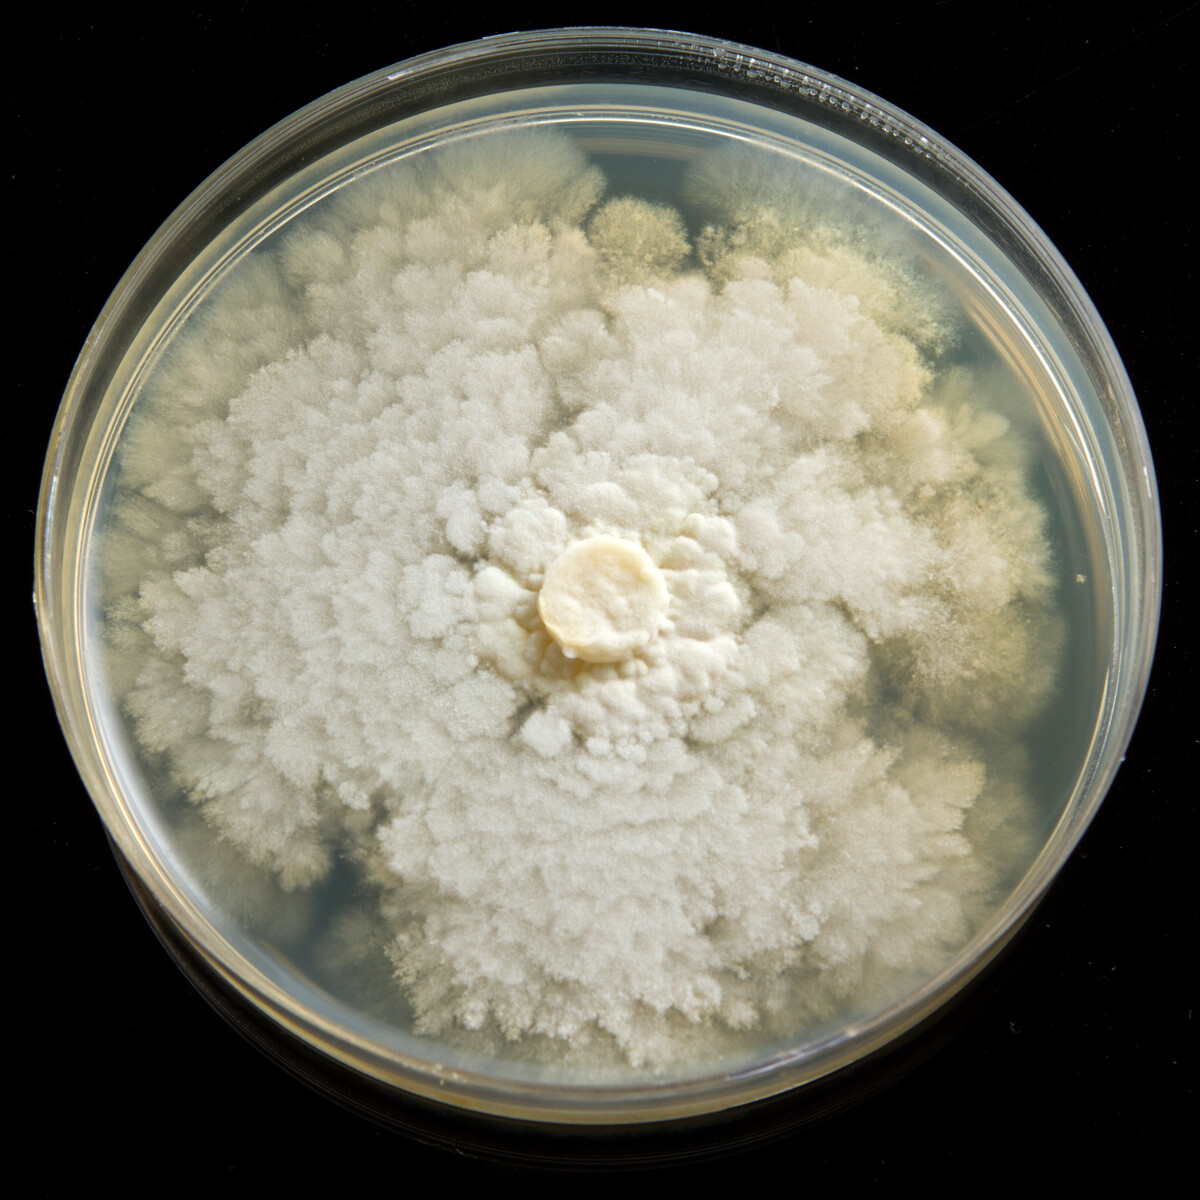

Christmas and other holiday cactuses are classic houseplants that, when given the right care, can live for generations. Lucky for us, that care is easy enough to give. Holiday cactuses have a reputation for being relatively disease-free, and they’re rarely troubled by pests. So, when you notice something wrong with your plant, it’s helpful to know what you’re up against.
Let’s take a look at the most common pests and diseases that afflict plants in the Schlumbergera family.
The Hardy Christmas Cactus

It’s likely by now that you know whether or not you have a true Christmas cactus or another variety of these popular holiday plants. (If not, you can learn how to identify them here.)
Holiday cactuses, as they’re called more often these days, are true cactuses in the family, Schlumbergera. There are only about a handful of Schlumbergera, all of them native to the mountainous coasts of Brazil.

Common Diseases & How to Treat Them
You’ll notice a common theme among diseases that attack Christmas cactuses. Most of them are some type of fungus that attacks the plant’s roots. It’s important to remember these plants do not tolerate consistently damp soil conditions.
Basal Stem Rot
Basal stem rot is a fungal disease caused by Fusarium fungi. As the name suggests, it affects the base of the plant’s stem.
Identification: Look for signs of brown or black discoloration at the base of the plant, right where the stem meets the soil. You’ll likely notice your plant appears droopy as the disease progresses.
Treatment: Remove affected parts immediately and repot the plant in fresh, well-draining soil. Ensure pots and tools are sterilized before reuse. Don’t over water! Most people respond to a wilting plant with water. Check the soil first. The plant is wilting not because it needs more water but because the roots are damaged and it can’t take up the water in the soil.
Botrytis Blight
This disease is caused by the Botrytis cinerea fungus. It thrives in humid conditions and affects many houseplants, including Christmas cactuses.
Identification: Watch for gray, moldy spots on leaves and flowers. You may also see fuzzy grayish-brown spores, especially in moist or poorly ventilated conditions.
Treatment: Remove all affected areas and dispose of them immediately. Increase air circulation around the plant, and avoid watering on the leaves and flowers. Fungicides labeled for Botrytis may also help if the infection persists.
Impatiens Necrotic Spot Virus (INSV)
INSV is a viral disease spread by thrips, a common houseplant pest.
Identification: Holiday cactuses infected with INSV quite often are symptomless. The plant may look distorted or stunted, but not much different beyond that. They can pass the virus on to other plants without ever displaying any symptoms.
Treatment: There is no cure for INSV. It’s best to destroy plants that have suffered from severe thrip infestation and display odd growth patterns.
Phytophthora Root Rot
This is a soil-borne disease caused by the Phytophthora fungus, affecting the roots and base of the Christmas cactus.
Identification: Symptoms include yellowing, wilting, and stunted growth despite watering. Roots may appear brown and mushy when removed from the soil. They will smell rotten as well.
Treatment: Repot the plant with sterile soil and a well-draining pot to prevent recurrence. Remove and dispose of any infected root material. Avoid overwatering, as Phytophthora thrives in soggy conditions.
Pythium Root Rot
Caused by Pythium fungi, this disease primarily affects the roots, especially in overly moist conditions.
Identification: The plant may look wilted or have stunted growth, and roots will appear blackened or mushy when examined.
Treatment: Remove the plant from its pot, trim away affected roots, and repot in fresh, well-draining soil. Reduce watering frequency and improve soil drainage.
Common Pests & How to Treat Them
Fungus Gnats
Identification: Fungus gnats are small flies often found around moist soil.
Symptoms of Infestation: Adult gnats flying around the plant and your home, as well as larvae in the soil (small, white, worm-like), can indicate an infestation. The larvae feed on roots, leading to poor plant growth and yellowing.

Treatment: Allow the soil to dry between waterings to reduce moisture, which discourages larvae. Apply a layer of sand on the soil surface to deter adult gnats from laying eggs, and consider using sticky traps for the adults. Pour hydrogen peroxide over the soil to kill any eggs.
Mealybugs
Identification: Mealybugs are small, white, cotton-like insects that gather on leaves, stems, and crevices.
Symptoms of Infestation: Sticky residue (honeydew) on the plant, white fuzzy patches, and general plant weakening are signs of a mealybug infestation.
Treatment: Wipe off visible mealybugs with a cotton swab dipped in rubbing alcohol. Use insecticidal soap or neem oil to treat the plant. Repeat treatments as needed, especially on the undersides of leaves and in hidden areas.
Scale
Identification: Scale insects look like small, brown or white bumps attached to the plant’s stems and leaves. They can be soft or hard, depending on the species.
Symptoms of Infestation: Yellowing or wilting leaves, sticky honeydew residue, and a buildup of small bumps on the plant surfaces indicate a scale infestation.
Treatment: Manually remove scale insects by gently scraping them off or wiping them with a cotton swab dipped in alcohol. Apply neem oil or insecticidal soap to the plant, focusing on areas where scale tends to hide.
Spider Mites
Identification: Spider mites are tiny, often red or brown, and can be difficult to see without a magnifying glass.

Symptoms of Infestation: Look for tiny yellow or white spots on leaves and fine webbing, usually on the underside of leaves. Infested plants may look dull or faded.
Treatment: Increase humidity around the plant, as spider mites thrive in dry conditions. Rinse the plant with a strong stream of water to dislodge mites (the shower works great), then apply insecticidal soap or neem oil. Repeat treatment until the infestation clears.
Thrips
Identification: Thrips are tiny, slender insects, often less than 1/20 inch long, and are usually yellow, brown, or black.

Symptoms of Infestation: Look for distorted, discolored, or scarred flowers and leaves, as well as tiny black specks (thrips’ feces) on the plant. You’ll often get bud blast with thrips.
Treatment: Prune and remove any infested flowers or leaves. Use insecticidal soap or neem oil to spray the plant thoroughly. Sticky traps can also help catch adult thrips.
Prevention is the Best Cure – Basic Christmas Cactus Care
Like most things, prevention is the best cure. Take care of your Christmas cactus well, and it’s likely you’ll never have to deal with any of these issues. These plants are fuss-free and tough.
Light

Like most tropical houseplants, Schlumbergera needs plenty of bright, indirect light. Six to eight hours a day, more to thrive and bloom. Of course, their light needs change in the fall as they gear up for blooming. You can learn more about that here.
Water
Many of the issues described above can be prevented with proper watering. Holiday cactuses do not like wet feet. Allow the top inch or two of soil to dry out between waterings, and you’ll be good to go. But remember, they also grow in a naturally humid environment. Keeping the pot on a pebble tray with water can provide the right amount of humidity.
Fertilizing
Plants that grow in the wild have an ever-changing availability of nutrients because organic matter is always breaking down and being added to the soil. Houseplants rely on us to provide nutrients in a small space. To ensure your plant receives the appropriate nutrients, use an organic liquid fertilizer meant specifically for houseplants. A couple of months before the plant blooms, switch to a fertilizer specifically meant for blooming plants.
Soil

Remember, these plants are cactus and won’t do as well in a traditional all-purpose potting mix. They prefer a potting mixture that is lightweight and quick-draining. Potting mixes for aroids are a good choice. You can also make your own potting mix quite easily. (My recipe for African Violet potting mix works equally as well for Christmas cactuses.)
Pot Size
Christmas cactuses are one of those rare plants that do best when left to get a little root-bound. They prefer their roots to be snug in their pot, much like how they would grow in their natural habitat. If your Christmas cactus was blooming regularly each year and has slowed, it will likely need to be repotted. You have two choices here. You can trim the roots back and prune the plant back, repotting it in the same pot. Or you can pot it up one size to give it room to grow larger. It’s important only to move up one pot size larger at a time. (Usually 1” in diameter bigger.)
Pruning
Prune your Christmas cactus just as it’s coming out of dormancy. This will encourage a bushier shape and plenty of new growth. New growth = more blossoms. You can learn how and when to prune your Christmas cactus here.
These beautiful plants will bloom year after year and decade after decade with a little effort and the right care, and hopefully, pests and diseases will be few and far between.

Get the famous Rural Sprout newsletter delivered to your inbox.
Join the 50,000+ gardeners who get timely gardening tutorials, tips and tasks delivered direct to their inbox.
